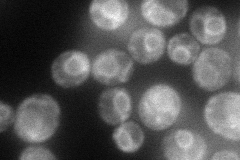
YOR377W
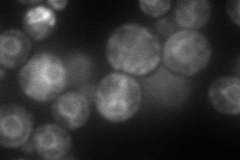
YOR377W
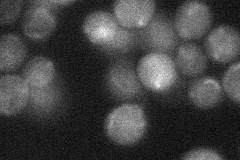
YOR377W
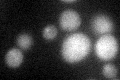
YOR377W

View description
Alcohol acetyltransferase with potential roles in lipid and sterol metabolism; responsible for the major part of volatile acetate ester production during fermentation
Localization:
Intensity:
Fold change:
Significance:
-
C’ GFP library in SD

below threshold17.97 -
N' NOP1pr-GFP in SD
ER73.3242 -
N' TEF2pr-mCherry in SD
ER107.271 -
N' NATIVEpr-GFP in SD
below threshold25.6485 -
N' TEF2pr-VC and Cyto-VN in SD

ER38.1619 -
C’ GFP library in SD+DTT
cytosol18.461.02No -
C’ GFP library in SD+H2O2

cytosol17.390.96No -
C’ GFP library in Starvation Media

cytosol14.060.78No -
C’ GFP library on the background of Pup2-DaMP

below threshold -
C’ GFP library on the background of CCT mutant

below threshold19.92331.10837No
